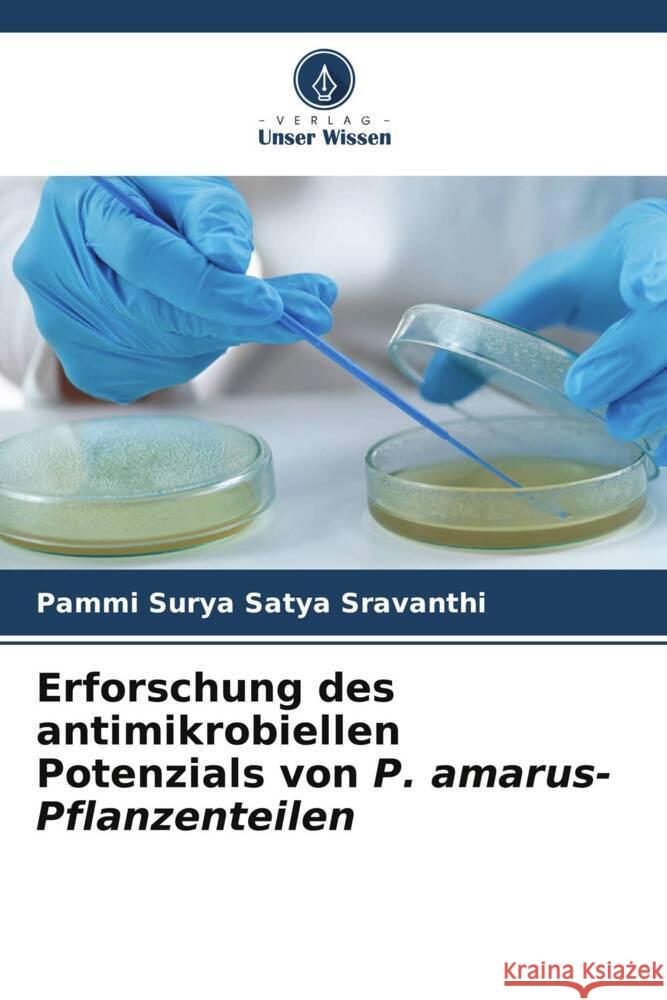
Erforschung des antimikrobiellen Potenzials von P. amarus-Pflanzenteilen Surya Satya Sravanthi, Pammi 9786137363010 Verlag Unser Wissen - książka

Erforschung des antimikrobiellen Potenzials von P. amarus-Pflanzenteilen » książka
Erforschung des antimikrobiellen Potenzials von P. amarus-Pflanzenteilen
ISBN-13: 9786137363010 / Niemiecki / Miękka / 2025 / 100 str.
Sekundäre Pflanzenstoffe haben sich aufgrund ihrer vielfältigen biologischen Eigenschaften, darunter antivirale, antibakterielle, antioxidative und krebsbekämpfende Wirkungen, als unschätzbare Quelle für Arzneimittel erwiesen. Sekundäre Pflanzenstoffe sind einzigartige Quellen für Arzneimittel, Lebensmittelzusatzstoffe, Aromastoffe und andere industrielle Anwendungen. Die kommerzielle Bedeutung dieser Sekundärmetaboliten hat in den letzten Jahren zu einem großen Interesse an der Erforschung ihrer Möglichkeiten geführt. Terpenoide, Alkaloide, Phenole und Flavonoide sind einige der bioaktiven Verbindungen, die zum medizinischen Wert einer Pflanze beitragen. Das Kraut Phyllanthus amarus ist in tropischen Ländern, darunter Indien, weit verbreitet. Es hat bedeutende traditionelle Verwendungszwecke. Angesichts des enormen Potenzials dieser Pflanze als Quelle für antimikrobielle Wirkstoffe versucht die vorliegende Studie, einen Überblick über die phytochemische Analyse und die antimikrobiellen Eigenschaften von Phyllanthus amarus zu geben, der für weitere Untersuchungen zu dieser Pflanze nützlich sein kann.